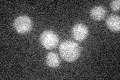
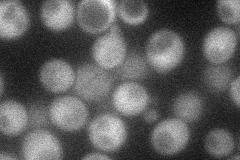
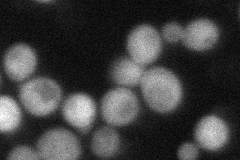

View description
Protein involved in proteolytic activation of Rim101p in response to alkaline pH; interacts with ESCRT-1 subunits Stp22p and Vps28p; essential for anaerobic growth; member of the arrestin-related trafficking adaptor family
Localization:
Intensity:
Fold change:
Significance:
-
C’ GFP library in SD
below threshold16.53 -
N' NOP1pr-GFP in SD
cytosol37.4358 -
N' TEF2pr-mCherry in SD
cytosol43.8437 -
N' NATIVEpr-GFP in SD

below threshold21.0702 -
N' TEF2pr-VC and Cyto-VN in SD

cytosol,punctate34.8443 -
C’ GFP library in SD+DTT

cytosol17.511.05No -
C’ GFP library in SD+H2O2

cytosol14.370.86No -
C’ GFP library in Starvation Media

cytosol16.010.96No -
C’ GFP library on the background of Pup2-DaMP

below threshold -
C’ GFP library on the background of CCT mutant

below threshold19.49171.17906No
